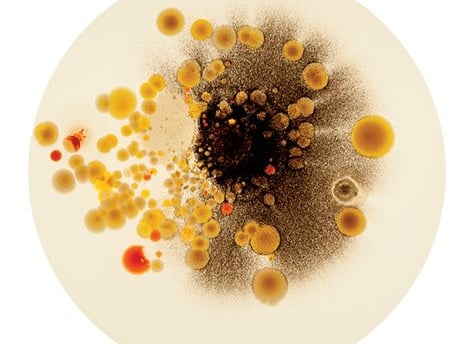

Votre article de blog
Description de l'article de blog :
10/23/20241 min read

Le contenu de mon article
THE LIVING HACK
Architecture & Design Consulting
CLIENTS
delphinerichon@gmail.com
Often in Paris & Mallorca
© 2024. All rights reserved.
INQUIRE
Create elegant spaces that promote luxury and comfort for all
Book a Design Day
Client Portal
Strategy & Design Services
Biodesign Strategy
Neurohacking
Pictures by Justine Robineau